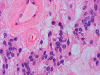

Squash
Squash
Squash
Frozen




Frozen
| A 40 year-old Man with Back
Pain and a Sacral Mass. November, 2004, Case 411-3. Home Page |
Adeboye O. Osunkoya, M.D.1, Jiang Qian, M.D., Ph.D.2 Last update July 30, 2003.
1 Department of Pathology, University of Oklahoma, Oklahoma City, OK and 2 Department of Pathology, Albany Medical College, Albany, NY.
Clinical information: The patient was a 40 year-old man with back pain for a long but unknown duration of time. MRI revealed a sharply circumscribed, lobulated, brightly enhancing, 3 cm mass in the cauda equina. The mass was removed and the followings are representative photomicrographs from the specimen. Panel A to C are taken from intraoperative cytologic preparation, D and E are taken from frozen section, F to H are taken from permanent sections.
 |
 |
 |
 |
||
|
A. Squash |
B. Squash |
C. Squash |
D. Frozen |
||
 |
 |
 |
|
||
|
G. Frozen |
H. | I. | J. |
Pathology of the case:
On cytologic preparations, there are clumps of tissue that do not smear out well (Panel A). On higher magnification, these tissue clusters are composed of large blobs of bluish, acellular, mucoid material admixed with cells with relatively uniform, bland nuclei and small amount of cytoplasm (Panel B). In the less tightly packed areas, the long cytoplasmic processes of the cells can be well appreciated (Panel C). These long processes are highly suggestive of a glial neoplasm. On frozen sections, the lesion is composed of multiple blobs of bluish, mucoid material surrounded by tumor cells (Panel D and E). Features of the paraffin sections are not that much different from that of the frozen sections (Panel F G H).
Comment: The nuclear feature is often better appreciated in cytologic preparation than frozen sections. This is well illustrated in this example.
| DIAGNOSIS: Myxopapillary ependymoma. (WHO grade I) |
Discussion: General Information Pathology Differential diagnosis
General Information
Myxopapillary ependymoma is a distinctive variant of ependymoma. It was first described as a separate entity by Kernohan in 1931 1. They are slowly growing gliomas with preferential occurrence in young adults and are usually restricted to the conus medullaris and filum terminale. Myxopillary ependymoma is a benign tumor of WHO histologic grade I 2. Anaplastic variants are practically unknown. They rarely invade nerve roots or the sacral bone. Myxopapillary ependymomas have also been described in extra-spinal locations including extradural/subcutaneous tissue 3, 4, 5, 6, 7, 8, 9, 10, cervical thoracic spine 11, lateral ventricle 12, 13, and the brain 14, 15, 16.
The age at presentation ranges from 6 to 82 years, however there is a tendency for the tumors to occur more frequently in young adults, with a mean age in the mid fourth decade of life11. Similar to ependymomas, there is evidence for a slight male preponderance. Myxopapillary ependymomas is an uncommon tumor that accounts approximately 5% of all ependymal tumors 17.The recognition of these tumors as a distinct entity is of considerable clinical importance, since they are more amenable to radical surgical resection than most other variants of ependymoma.
The most common clinical manifestations of myxopapillary ependymomas of the filum terminale is low back pain, which may be accompanied by sciatic radiation or other symptoms and signs of lumbosacral radiculopathy. There may be associated lower limb sensory disturbance with a lower sensory level and urinary sphincter disturbances 18.
Myxopapillary ependymomas are presumed to arise from the ependymal cell nests normally present in the filum terminale. The reason for the exuberant myxopapillary appearance in these tumors remains a mystery. The light microscopic features suggest a progressive distortion of normal ependymal architecture by an accumulation of myxoid material in perivascular spaces.
Direct secretion by the tumor cells 19 and vascular extravasation via endothelial fenestrations 15 are proposed as possible mechanisms of the deposition of the myxoid material. There is however ultrastructural evidence that the material may actually result from excess basement membrane production around the tumor cells 20. The fact that collagenous elements abut directly onto ependymal cells in the filum terminale, suggests that the abnormal juxtaposition of collagen may induce basement membrane production 20. Tissue culture studies of rat spinal cord have demonstrated basement membrane production at the interphase between neuroglial elements and substrate collagen 21. Organ culture of myxopapillary ependymomas has shown an increase in basement membrane material closely related to the collagen of the extracellular space 22.
Macroscopic: Grossly, cauda equina myxopapillary ependymomas are typically elongated, sausage shaped tumors with a relatively smooth lobulated surface. The tumors vary in size and could be 10 cm or more in greatest dimension 23. Large tumors are associated with destruction of the sacrun. Most tumors in this locale are well defined and fairly well circumscribed with compression and displacement of the adjacent cauda equina nerve roots. Cut section reveals a lobulated, soft and grayish appearance with focal areas of recent and old hemorrhage. Calcification is not seen as frequently as in typical ependymomas.
Histopathology: The salient feature of myxopapillary ependymomas is a rich, thin walled micropapillary bundle surrounded by a single of epithelium that varies from low cuboidal to columnar. The cells typically have rounded nuclei with a delicate, rather open chromatin and a moderate amount of amphophilic cytoplasm. The cores of the papillae consist of blood vessels surrounded by a variable amount of mucinous matrix. The amount varies from small to substantial. The vessels are characterized by extensive thickening and hyalinization of the vessel wall. Ins some tumors, there are components with features of conventional ependymomas 24. Mitotic activity is very low or absent 25. Myxopapillary ependymomas usually have sharply defined margins, although nerve roots may be enclosed. A proportion of tumors are surrounded by a condensed connective tissue capsule 11.
Immunohistochemistry: Immunohistochemical reactions for glial fibrillary acidic protein (GFAP), S-100 protein and vimentin are usually positive whereas immunoreactivity for cytokeratins typically is absent 26, 27, 28, 29, 30.
Electron microscopy: Ultrastructural studies demonstrate cilia, complex interdigitations and abundant basement membrane substance. A distinctive feature of some examples is the aggregation of microtubules within rough endoplasmic reticulum complexes 31 . Occasionally polar inversion may be found, in which microvillus-bearing apical surface of one cell abuts directly against the flattened basal surface of an adjacent cell 32.
Molecular Pathology and cytogenetics: Very few isolated cases with specific molecular and cytogenetic abnormalities have been documented. A rearranged chromosome 1p has been noted in a single case 33. Dicentric chromosomes and deletions of chromosome 11q in a subcutaneous sacroccoygeal myxopapillary ependymomas has been reported 34. A molecular analysis of 6 myxopapillary ependymomas for allelic deletions on chromosomes 10q and 22q and for point mutations of the NF2 and PTEN tumor suppressor genes did not reveal any changes at these loci 35.
Differential diagnosis
Cauda equina paraganglioma: These tumors are usually well circumscribed, lobulated tumors within the sacral canal that can be difficult to distinguish from myxopapillary ependymomas on a clinical, radiological or surgical basis. On histology, they lack the well organized papillary architecture and mucinous matrix of myxopapillary ependymomas and are identified by their typical pattern of cell nests enclosed by reticulin. Immunohistochemically, paragangliomas differ from ependymomas in their expression of neuronal antigens such as synaptophysin, neurofilament 36. Cytokeratin is also expressed in paragangliomas 37. The sustentacular cells in paraganglioma are positive for S-100 protein.
Metastatic adenocarcinoma: Adenocarcinomas may have mucin pools and papillary architecture. Intracellular mucin production can be easily demonstrated by mucin stain when present. Substantial pleomorphism and other features indicating of malignant biological potentials such as necrosis are present in metastatic carcinoma. In addition, metastatic carcinomas are positive for cytokeratin 38. While expression of cytokeratin may be more diffuse and strong in carcinoma, a variable degree of expression of cytokeratin can also occur in ependymoma and the result must be interpreted with care. Epithelial membrane antigen (EMA) is often positive in ependymal tumors and would not be a helpful tool in distinguishing the two entities.
Chordoma: These tumors are relatively common in the cauda equine region and show a prominent myxoid matrix which is positive for Alcian blue. Physaliphorous cytoplasmic vacuolation is present in at least some tumor cells. In contrast to myxopapillary ependymoma that adapt a papillary growth pattern, cells in chordoma arrange in chords and are embedded in the myxoid matrix. Cells in chordoma are negative for GFAP but positive for cytokeratins 39.
Chondroma/Chondrosarcoma: Most chondromas and low grade chondrosarcomas can be easily distinguished from myxopapillary ependymomas by the presence of typical cartilaginous architecture with dispersed tumor cells in lacunar spaces. These tumors are negative for GFAP 30.
Myxopapillary ependymomas show good outcome with more than 10 years survival post partial or complete resection 11. Late recurrence and distant metastasis are very uncommon 40. Subcutaneous sacrococcygeal myxopapillary ependymomas appear to be associated with a significant rate of regrowth and distant metastasis 41.
Reference:
Kernohan JW . Primary tumours of the spinal cord and intradural filum terminale. In cytology and cellular pathology of the nervous system. Vol 3 , 1932: 993-1025.
Wiestler OD et al. Myxopapillary ependymoma. In: WHO Pathology and Genetics Tumours of the nervous system. IARC Press 2000: 78-79.
Kline MJ, Kays DW, Rojiani AM. Extradural myxopapillary ependymoma: report of two cases and review of the literature. Pediatr Pathol Lab Med 1996;16:813-822
Helwig EB, Stern JB. Subcutaneous sacrococcygeal myxopapillary ependymoma: a clinicopathologic study of 32 cases. Am J Clin Pathol 1984;81:156-161
Kramer GWPM, Rutten E, Sloof J. Subcutaneous sacrococcygeal ependymoma with inguinal lymph node metastasis. J Neurosurg 1988;68:474-477
Agapitos E, Kavantzas N, Karaitianos J, Davaris P. Subcutaneous sacrococcygeal myxopapillary ependymoma: a case report. Arch Anat Cytol Pathol 1995;43:157-159
Ciraldo AV, Platt MS, Agamanolis DP, et al. Subcutaneous myxopapillary ependymomas and ependymal rests in infants and children. J Pediatr Surg 1986;21:49-52
Pulitzer DR, Martin PC, Collins PC, et al. Subcutaneous sacrococcygeal ("myxopapillary") ependymal rests. Am J Surg Pathol 1988;12:672-677
Anderson MS. Myxopapillary ependymomas presenting in the soft tissue over the sacrococcygeal region. Cancer. 1966 19:585-90.
Domingues RC, Mikulis D, Swearingen B, Tompkins R, Rosen BR. Subcutaneous sacrococcygeal myxopapillary ependymoma: CT and MR findings (letter). AJNR Am J Neuroradiol 1991;12:171-172.
Sonneland PR, Scheithauer BW, Onofrio BM. Myxopapillary ependymoma. A clinicopathologic and immunocytochemical study of 77 cases. Cancer. 1985 Aug 15;56(4):883-93.
Matyja E, Naganska E, Zabek M, Koziara H. Myxopapillary ependymoma of the lateral ventricle with local recurrences: histopathological and ultrastructural analysis of a case. Folia Neuropathol. 2003;41:51-7.
Sato H, Ohmura K, Mizushima M, Ito J, Kuyama H. Myxopapillary ependymoma of the lateral ventricle. A study on the mechanism of its stromal myxoid change. Acta Pathol Jpn. 1983 33:1017-25.
Liu HM, Boogs J, Kidd J. Ependymomas of childhood. I. Histological survey and clinicopathological correlation. Childs Brain. 1976 2:92-110.
Chow CW, Brittingham J. Perivascular pseudorosettes in childhood brain tumours: an ultrastructural and immunohistochemical study. Pathology. 1987 19:12-6.
Warnick RE et al. Intracranial myxopapillary ependymoma: case report. J Neurooncol. 1993 Mar;15(3):251-6.
Davis C, Barnard RO. Malignant behavior of myxopapillary ependymoma. Report of three cases. J Neurosurg. 1985 62:925-9.
Chan HS, Becker LE, Hoffman HJ, Humphreys RP, Hendrick EB, Fitz CR, Chuang SH. Myxopapillary ependymoma of the filum terminale and cauda equina in childhood: report of seven cases and review of the literature. Neurosurgery. 1984 14:204-10.
Miller C. The ultrastructure of the conus medullaris and filum terminale. J Comp Neurol. 1968 Apr;132(4):547-66.
Rawlinson DG, Herman MM, Rubinstein LJ. The fine structure of a myxopapillary ependymoma of the filum terminale. Acta Neuropathol (Berl). 1973 25:1-13.
Wolff JR, Hosli E, Hosli L. Basement membrane material and glial cells in spinal cord cultures of newborn rats. Brain Res. 1971 32:198-202.
Rawlinson DG, Rubinstein LJ, Herman MM. In vitro characteristics of a myxopapillary ependymoma of the filum terminale maintained in tissue and organ culture systems. Light and electron microscopic observations. Acta Neuropathol (Berl). 1974 27:185-200.
Rivierez M, Oueslati S, Philippon J, Pradat P, Foncin JF, Muckensturm B, Dorwling-Carter D, Cornu P. Ependymoma of the intradural filum terminale in adults. Neurochirurgie. 1990;36(2):96-107.
Specht CS, Smith TW, DeGirolami U, Price JM. Myxopapillary ependymoma of the filum terminale. A light and electron microscopic study. Cancer. 1986 58:310-7.
Prayson RA. Myxopapillary ependymomas: a clinicopathologic study of 14 cases including MIB-1 and p53 immunoreactivity. Mod Pathol. 1997 10:304-10.
Vege KD, Giannini C, Scheithauer BW. The immunophenotype of ependymomas. Appl Immunohistochem Mol Morphol. 2000 8:25-31.
Kaneko Y, Takeshita I, Matsushima T, Iwaki T, Tashima T, Fukui M. Immunohistochemical study of ependymal neoplasms: histological subtypes and glial and epithelial characteristics. Virchows Arch A Pathol Anat Histopathol. 1990 417:97-103.
Cruz-Sanchez FF, Rossi ML, Hughes JT, Cervos-Navarro J. An immunohistological study of 66 ependymomas. Histopathology. 1988 13:443-54.
Kimura T, Budka H, Soler-Federsppiel S. An immunocytochemical comparison of the glia-associated proteins glial fibrillary acidic protein (GFAP) and S-100 protein (S100P) in human brain tumors. Clin Neuropathol. 1986 5:21-7.
Coffin CM, Swanson PE, Wick MR, Dehner LP. An immunohistochemical comparison of chordoma with renal cell carcinoma, colorectal adenocarcinoma, and myxopapillary ependymoma: a potential diagnostic dilemma in the diminutive biopsy. Mod Pathol. 1993 6:531-8.
Ho KL. Microtubular aggregates within rough endoplasmic reticulum in myxopapillary ependymoma of the filum terminale. Arch Pathol Lab Med. 1990 114:956-60.
Wolff M, Santiago H, Duby MM. Delayed distant metastasis from a subcutaneous sacrococcygeal ependymoma. Case report, with tissue culture, ultrastructural observations, and review of the literature. Cancer. 1972 30:1046-67.
Sawyer JR, Crowson ML, Roloson GJ, Chadduck WM. Involvement of the short arm of chromosome 1 in a myxopapillary ependymoma. Cancer Genet Cytogenet. 1991 54:55-60.
Sawyer JR, Miller JP, Ellison DA. Clonal telomeric fusions and chromosome instability in a subcutaneous sacrococcygeal myxopapillary ependymoma. Cancer Genet Cytogenet. 1998 100:169-75.
Ebert C, von Haken M, Meyer-Puttlitz B, Wiestler OD, Reifenberger G, Pietsch T, von Deimling A. Molecular genetic analysis of ependymal tumors. NF2 mutations and chromosome 22q loss occur preferentially in intramedullary spinal ependymomas. Am J Pathol. 1999 155:627-32.
Bak J, Olsson Y, Grimelius L, Spannare B. Paraganglioma of the cauda equina. A case report and review of the literature. APMIS. 1996 104:234-40.
Labrousse F, Leboutet MJ, Petit B, Paraf F, Boncoeur-Martel MP, Moreau JJ, Catanzano G. Cytokeratins expression in paragangliomas of the cauda equina. Clin Neuropathol. 1999 18:208-13.
Moritani S, Kushima R, Bamba M, Kobayashi TK, Oka H, Fujimoto M, Hattori T, Okabe H. Highly anaplastic extraventricular ependymoma arising in an adult, mimicking metastatic adenocarcinoma with heavy stromal inflammation and emperiporesis. Pathol Int. 2003 53:539-46.
Miettinen M, Lehto VP, Dahl D, Virtanen I. Differential diagnosis of chordoma, chondroid, and ependymal tumors as aided by anti-intermediate filament antibodies. Am J Pathol. 1983 112:160-9.
Morantz RA, Kepes JJ, Batnitzky S, Masterson BJ. Extraspinal ependymomas. Report of three cases. J Neurosurg. 1979 51:383-91.
Lemberger A, Stein M, Doron J, Fried G, Goldsher D, Feinsod M. Sacrococcygeal extradural ependymoma. Cancer. 1989 64:1156-9.